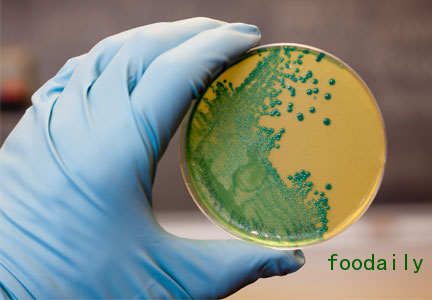

2018年,CDC(美国疾病控制与预防中心)将开始使用全基因组测序来鉴定沙门氏菌、弯曲杆菌和大肠杆菌等病原体
在最近召开的全球食品安全会议上,关于行业协作、学术界及监管机构的小组讨论本来可能会解决李斯特菌的控制问题,但却迅速转向讨论全基因组测序技术及其对食品安全未来的意义。
Robert Tauxe博士是位于亚特兰大的美国疾病控制与预防中心食源性、水源性以及环境疾病司司长,他表示,早在2013年,CDC就启动了一项使用全基因组测序的试点项目。结果显示,关于李斯特菌 ,我们还有很多要学习、要发现的未知。

Robert Tauxe博士,CDC食源性、水源性以及环境疾病司司长
他在3月1日的会议上表示:“我们正在寻找并解决更多的疫情,但是需要在它们势头很小的时候就发现。”
Tauxe博士接着提到,CDC将在2018年扩大全基因组测序的使用范围,用来确定其他诸如沙门氏菌、弯曲杆菌和大肠杆菌等病原体。
“全基因组测序是疫情监测与研究领域的重要一步。”
CDC对该技术的使用可能会使食品和饮料制造商受到约束,因为监管机构将可以获得更强大的技术来监测和追踪疫情。在小组会议期间出现了一个关于食品生产商如何使用该技术的问题,但根据调查结果,他们并不会面临更多的监管与审查。
美国食品药品监督管理局(FDA)食品安全和应用营养中心的资深科学顾问Mickey Parish表示,该机构将鼓励工业为达到自身目的而采用全基因组测序。

Mickey Parish —FDA食品安全和应用营养中心资深科学顾问
他说:“我们认识到,他们可能希望通过观察腐败的生物体来开始尝试的第一步,以便使该技术变得更加适用,之后再发展到病原体领域。”
“我们正在将其用于监管目的。因此,谨慎的公司可能会决定,如果FDA正以这种方式使用它,那我们也需要采用相同的技术来保持领先。”
伊利诺伊大学香槟分校食品微生物学助理教授Matthew Stasiewicz博士说,他进行的研究涉及寻找并确定全国30个熟食店产品中李斯特菌的来源,全基因组测序可能会帮助改善食物中李斯特菌鉴别与确认。

伊利诺斯大学食品微生物学助理教授Matthew Stasiewicz博士
他说:“全基因组测序可以指示持续性食物应变是否更有可能。”他补充说,该过程还可以帮助操作者提出关于病原体可能发生位置的假设。
Parish博士补充说,FDA已经设立了一个专注于全基因组测序的理事会,与行业利益相关者共同讨论技术及其应用。
尽管整个基因组测序的使用成为贯穿整个会议的主题,但演讲者仍然侧重于如何降低食品行业所面临的降低李斯特菌病原体发病率的挑战。
瑞士沃维雀巢公司副总裁兼质量管理负责人Anthony Huggett表示:“食品行业中所有人都在担心受到这样的打击。因此整个行业的合作应对是十分必要的。”
Tauxe博士说,美国每年约发生800例李斯特菌感染,几乎所有被感染的人都会住院,约有16%被感染者死亡。确定的李斯特菌来源主要包括生奶、软奶酪和绿豆芽。最近又发现,像焦糖苹果和冰淇淋这种新鲜的食物也出现了相关疫情。

确定为李斯特菌来源的主要食物包括生奶和软奶酪。
一个在控制李斯特菌方面取得成功的行业是加工肉制品。Food Safety by Design咨询公司总裁&加工肉类制造商Land O'Frost(位于印第安纳州明斯特市)公司研究部副总裁John Butts博士认为,加工肉类公司已经经过了美国农业部食品安全检验局近25年的李斯特菌检测,随着时间的推移,阳性结果的比例已经逐步下降了。

John Butts博士—Land O'Frost公司研究部副总裁
他说:“要做到这一点这很简单——杀灭寄主、控制有机体的转移、部署过程管理技术。”
他所说的最佳做法已被证明对肉类行业中李斯特菌的控制至关重要,其中还包括地面应当洁净干燥且没有裂缝。设备应当可拆卸或面拆卸以进行清洁。小零件、设备组件以及手动工具等可使用非就地清洗的方式。大型设备应采用热杀菌。
公司还应考虑安装关键的空气处理系统。——“虽然我们花了两倍的钱,但是我们收到了巨大的回报。”
必须考虑加工区上方的天花板空间、原料和即食原料的分离。——“我不是在说地板上划道黄线就可以了,而是说需要真正的隔离。”

美国冷冻食品研究所监管和技术事务高级副总裁Donna Garren博士
美国冷冻食品研究所(位于弗吉尼亚州麦克莱恩)监管和技术事务高级副总裁Donna Garren博士强调,当加工肉类行业通力合作时,他们将看到李斯特菌感染事件数量下降这一成果。
她指出:“这是一个全球性问题,我们需要共同努力。”
本文来源为FOODAILY每日食品网,如转载请注明出处,违者必究。








评论